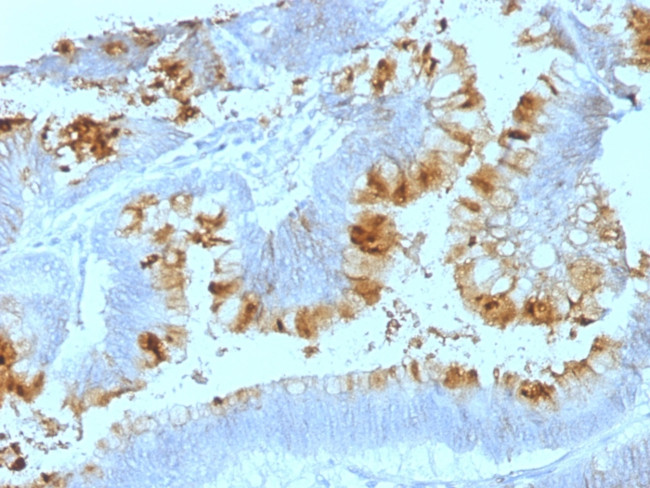

Search
NeoBiotechnologies
Lewis A (Blood Group Antigen) Monoclonal Antibody (SPM522)
{{$productOrderCtrl.translations['antibody.pdp.commerceCard.promotion.promotions']}}
{{$productOrderCtrl.translations['antibody.pdp.commerceCard.promotion.viewpromo']}}
{{$productOrderCtrl.translations['antibody.pdp.commerceCard.promotion.promocode']}}: {{promo.promoCode}} {{promo.promoTitle}} {{promo.promoDescription}}. {{$productOrderCtrl.translations['antibody.pdp.commerceCard.promotion.learnmore']}}
产品信息
MSM1XX-311-P0
种属反应
宿主/亚型
分类
类型
克隆号
抗原
偶联物
形式
浓度
规格
纯化类型
保存液
内含物
保存条件
运输条件
靶标信息
The Lewis histo-blood group system comprises a set of fucosylated glycosphingolipids that are synthesized by exocrine epithelial cells and circulate in body fluids. The glycosphingolipids function in embryogenesis, tissue differentiation, tumor metastasis, inflammation, and bacterial adhesion. They are secondarily absorbed to red blood cells giving rise to their Lewis phenotype. This gene is a member of the fucosyltransferase family, which catalyzes the addition of fucose to precursor polysaccharides in the last step of Lewis antigen biosynthesis. It encodes an enzyme with alpha(1,3)-fucosyltransferase and alpha(1,4)-fucosyltransferase activities. Mutations in this gene are responsible for the majority of Lewis antigen-negative phenotypes. Multiple alternatively spliced variants, encoding the same protein, have been found for this gene.
仅用于科研。不用于诊断过程。未经明确授权不得转售。
篇参考文献 (0)
生物信息学
蛋白别名: 3-galactosyl-N-acetylglucosaminide 4-alpha-L-fucosyltransferase 3; 3-galactosyl-N-acetylglucosaminide 4-alpha-L-fucosyltransferase FUT3; 4-fucosyltransferase; 4-galactosyl-N-acetylglucosaminide 3-alpha-L-fucosyltransferase; alpha-(1,3/1,4)-fucosyltransferase; Alpha-3-fucosyltransferase FUT3; Blood group Lewis alpha-4-fucosyltransferase; Fucosyltransferase 3; fucosyltransferase 3 (galactoside 3(4)-L-fucosyltransferase, Lewis blood group); Fucosyltransferase III; FucT-III; galactoside 3(4)-L-fucosyltransferase; Lewis FT; Lewis Y; unnamed protein product
基因别名: CD174; FT3B; FucT-III; FUT3; LE; Les
UniProt ID: (Human) P21217
Entrez Gene ID: (Human) 2525